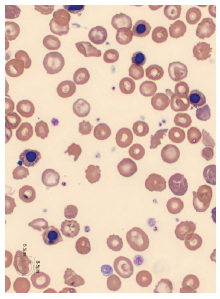
Hematology Case Study -Thalassemia Image #2

Hematology Case Study - Thalassemia
Download PDF
The patient (see PDF) is a 37 year old male with a history of thalassemia. The initial analysis of this sample shows an impedance platelet count of 1,529 x 103/μL using the impedance channel (PLT-I) and a “Platelet Abnormal Distribution” flag. The reflex analysis in the PLT-F channel provides an accurate platelet count without interference from schistocytes. Smear review confirmed the marked poikilocytosis and red cell morphology consistent with thalassemia.
Due to the positioning of the lower RBC discriminator and no separation between the RBC and platelet populations, an “RBC Abn Distribution” flag was generated. In this sample, the flag caused asterisks to be placed by the RBC indices and suppressed the RDW-SD. Note that the presence of the “RBC Abn Distribution” flag may cause some flags, such as the “Fragments?” flag, to be suppressed.
Due to the abnormal platelet histogram, the MPV was suppressed. However the Immature Platelet Fraction (IPF) demonstrates that newly produced platelets are being released by the bone marrow in response to the decreased platelet count.

The clinical applications or uses presented in these materials, including case studies, are provided for illustration purposes only. Prior to using any Sysmex device, please review the manufacturer’s instructions use. It is the healthcare provider’s responsibility to determine applicability in routine clinical practice.
Keep reading: Download PDF
